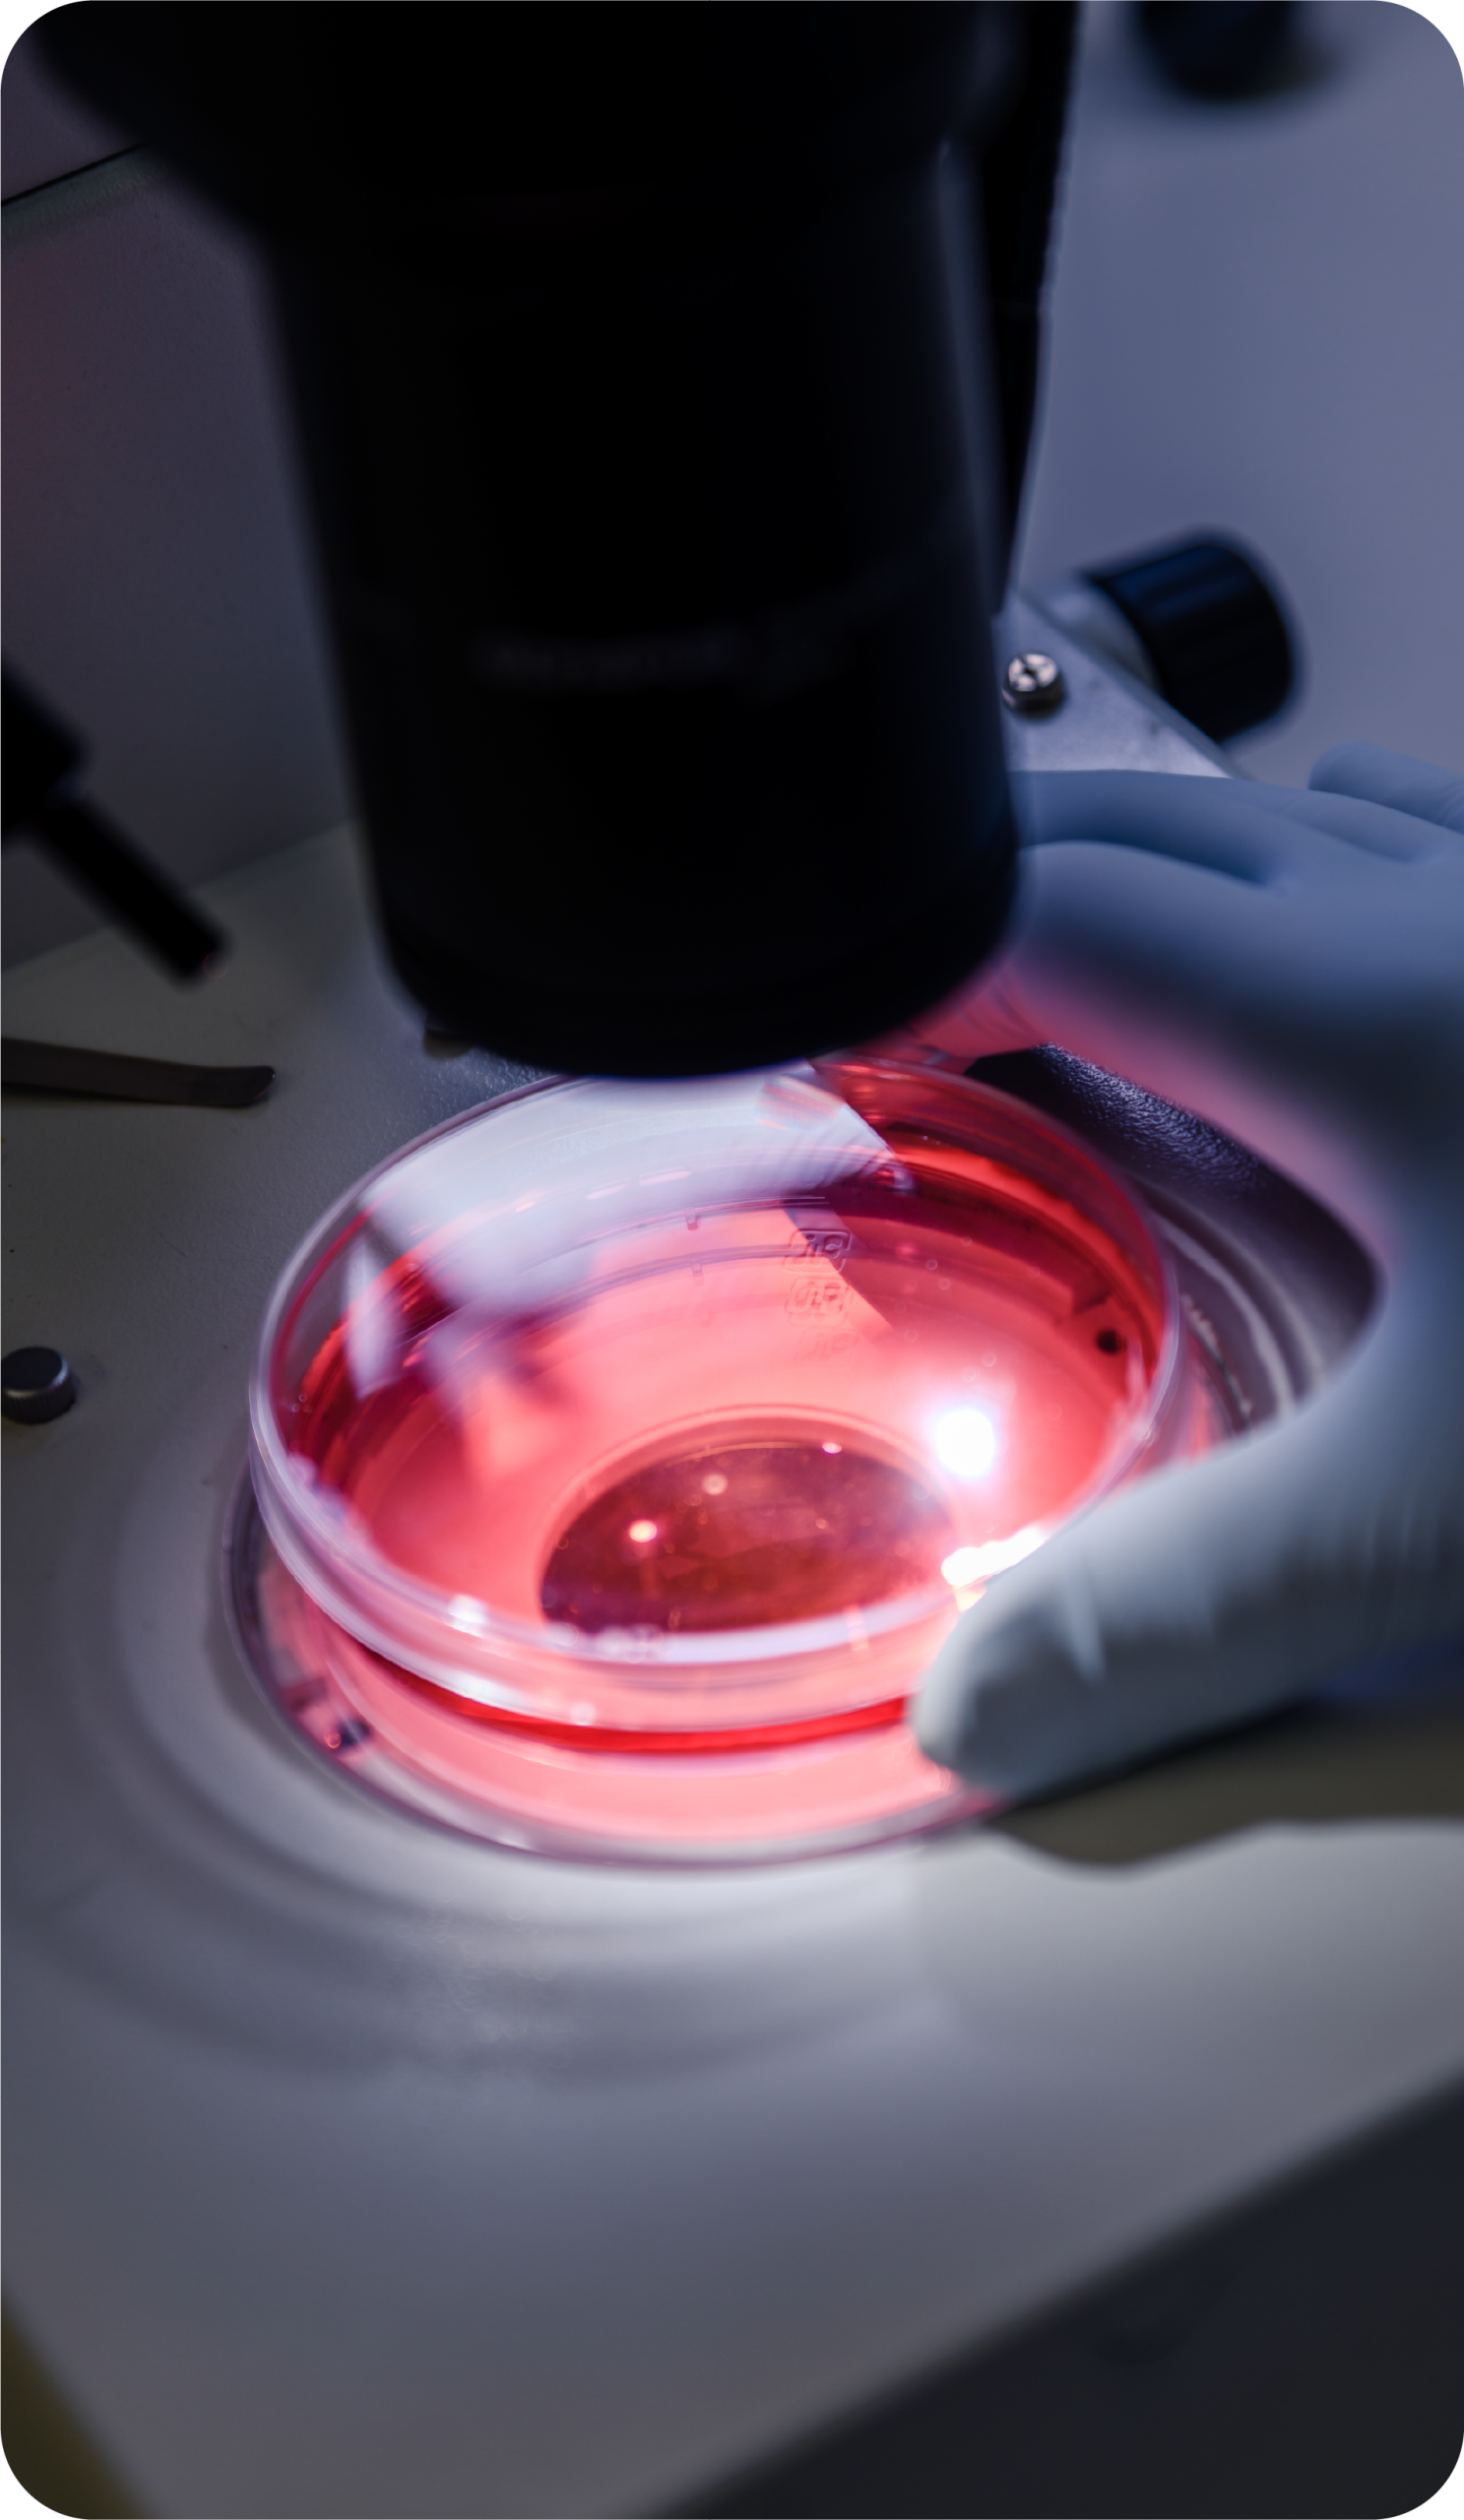

Ofrece una visión experta y concisa de las últimas tendencias en 51 disciplinas del conocimiento, desde las ciencias exactas hasta las ciencias sociales.

Sintetiza la literatura más influyente en 51 campos, permitiendo a investigadores y docentes ponerse al día en temas complejos con la mínima inversión de tiempo.

Va más allá del resumen al identificar controversias, desafíos no resueltos y las futuras direcciones de la investigación en cada área.

Descubra cómo mantener los datos MARC actualizados y precisos en el Sistema de Gestión de Aprendizaje (LMS) es fundamental para una experiencia de aprendizaje eficiente.

Los detectores de IA, también llamados comprobadores de IA, detectores de ChatGPT o detectores de escritura generada por IA, son herramientas diseñadas para analizar un texto y determinar si es escrito por una persona o generado por inteligencia artificial.

When she was a teenager and the pain became agonizing, Katherine “Katie” Burns would crawl under her bed and lie bellydown on the wood floor. She’d clutch a calculator and do “random” math problems to distract herself from the feeling that invisible hands were wringing out her uterus like a washcloth.

Descubra cómo mantener los datos MARC actualizados y precisos en el Sistema de Gestión de Aprendizaje (LMS) es fundamental para una experiencia de aprendizaje eficiente.

Los detectores de IA, también llamados comprobadores de IA, detectores de ChatGPT o detectores de escritura generada por IA, son herramientas diseñadas para analizar un texto y determinar si es escrito por una persona o generado por inteligencia artificial.

When she was a teenager and the pain became agonizing, Katherine “Katie” Burns would crawl under her bed and lie bellydown on the wood floor. She’d clutch a calculator and do “random” math problems to distract herself from the feeling that invisible hands were wringing out her uterus like a washcloth.